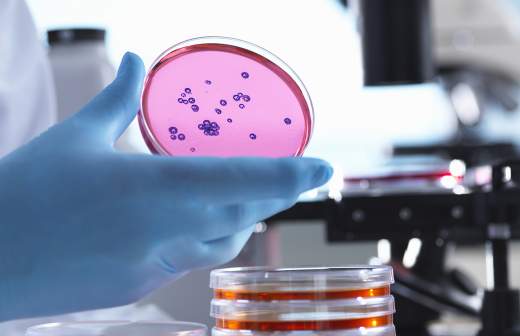

Russia has developed an AI device for asthmatics

A Russian technology startup with the support of the National Technology Initiative (NTI) has created a device for early diagnosis and monitoring of lung diseases such as asthma, COPD and others. It analyzes breathing data using artificial intelligence, quickly identifies organ abnormalities and evaluates the effectiveness of treatment and is able to predict an exacerbation of the patient's condition.
The main advantage of the new product is the speed and clarity of the results. Unlike conventional picoflowmeters (meters of peak exhalation velocity) or spirometers (meters of the volume of air coming from the lungs at the greatest exhalation after the greatest inhalation), which show only individual numbers (for example, exhalation volume), this device generates a detailed report with graphs and metrics ("scores") in a minute. It's like a smart glucose meter used by diabetics, but only for asthmatics: the doctor and the patient do not receive raw data, but interpreted health information with additional recommendations from AI.
"For doctors, it is a tool for accurate diagnosis during admission, without unnecessary examinations. Patients will be able to monitor their condition at home, reducing the risk of complications. In the long term, such devices will help reduce the cost of treating chronic lung diseases in the country," said Sergey Davydov, technical director of the startup.
The developers plan to conduct clinical trials with Sechenov University, then register the device with Roszdravnadzor, after which they will launch mass production for clinics and telemedicine services. There is already a prototype of the device, laboratory tests and the first pilot studies have been conducted, and a patent has also been obtained for it.
Experts note that the device is able to reduce the risk of complications, but they warn you not to self—medicate and rely solely on the gadget.
Переведено сервисом «Яндекс Переводчик»